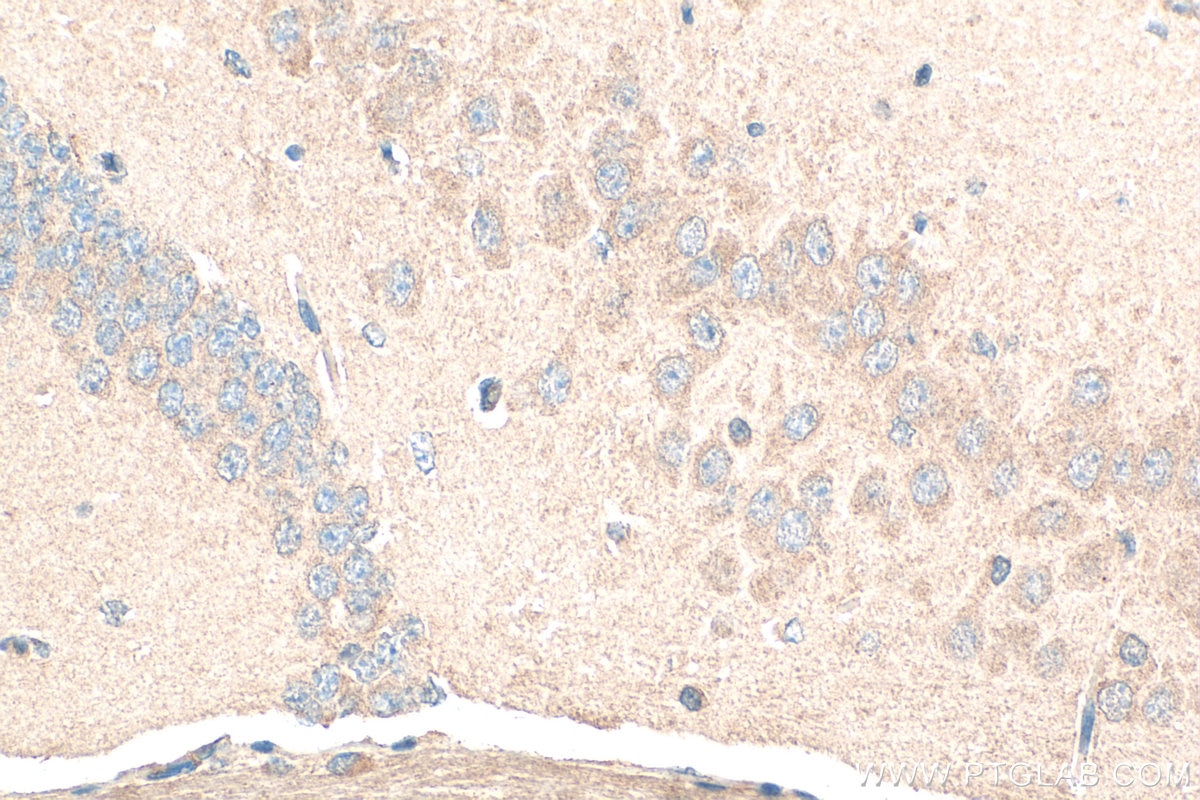

Tested Applications
| Positive WB detected in | human brain tissue |
| Positive IP detected in | mouse brain tissue |
| Positive IHC detected in | human gliomas tissue, human brain tissue, mouse brain tissue Note: suggested antigen retrieval with TE buffer pH 9.0; (*) Alternatively, antigen retrieval may be performed with citrate buffer pH 6.0 |
Recommended dilution
| Application | Dilution |
|---|---|
| Western Blot (WB) | WB : 1:500-1:1000 |
| Immunoprecipitation (IP) | IP : 0.5-4.0 ug for 1.0-3.0 mg of total protein lysate |
| Immunohistochemistry (IHC) | IHC : 1:50-1:500 |
| It is recommended that this reagent should be titrated in each testing system to obtain optimal results. | |
| Sample-dependent, Check data in validation data gallery. | |
Published Applications
| IF | See 1 publications below |
Product Information
13040-1-AP targets GRID1 in WB, IHC, IF, IP, ELISA applications and shows reactivity with human, mouse, rat samples.
| Tested Reactivity | human, mouse, rat |
| Cited Reactivity | mouse |
| Host / Isotype | Rabbit / IgG |
| Class | Polyclonal |
| Type | Antibody |
| Immunogen |
CatNo: Ag3694 Product name: Recombinant human GRID1 protein Source: e coli.-derived, PGEX-4T Tag: GST Domain: 24-348 aa of BC039263 Sequence: IHIGAIFEENAAKDDRVFQLAVSDLSLNDDILQSEKITYSIKVIEANNPFQAVQEACDLMTQGILALVTSTGCASANALQSLTDAMHIPHLFVQRNPGGSPRTACHLNPSPDGEAYTLASRPPVRLNDVMLRLVTELRWQKFVMFYDSEYDIRGLQSFLDQASRLGLDVSLQKVDKNISHVFTSLFTTMKTEELNRYRDTLRRAILLLSPQGAHSFINEAVETNLASKDSHWVFVNEEISDPEILDLVHSALGRMTVVRQIFPSAKDNQKCTRNNHRISSLLCDPQEGYLQMLQISNLYLYDSVLMLANAFHRKLEDRKWHSMAS Predict reactive species |
| Full Name | glutamate receptor, ionotropic, delta 1 |
| Calculated Molecular Weight | 1009 aa, 112 kDa |
| Observed Molecular Weight | 100-112 kDa |
| GenBank Accession Number | BC039263 |
| Gene Symbol | GRID1 |
| Gene ID (NCBI) | 2894 |
| RRID | AB_10638439 |
| Conjugate | Unconjugated |
| Form | Liquid |
| Purification Method | Antigen affinity purification |
| UNIPROT ID | Q9ULK0 |
| Storage Buffer | PBS with 0.02% sodium azide and 50% glycerol, pH 7.3. |
| Storage Conditions | Store at -20°C. Stable for one year after shipment. Aliquoting is unnecessary for -20oC storage. 20ul sizes contain 0.1% BSA. |
Background Information
GRID1 (Glutamate Ionotropic Receptor Delta Type Subunit 1) is a protein-coding gene that belongs to the family of ionotropic glutamate receptors. These receptors are crucial for rapid excitatory synaptic transmission and synaptic plasticity in the central nervous system. GRID1 is primarily expressed in various brain regions, including the cortex, hippocampus, amygdala, striatum, thalamus, nucleus accumbens, lateral hooked nucleus, and dorsal raphe nucleus. In the hippocampus, GRID1 is specifically expressed in the granule cells of the dentate gyrus.
Protocols
| Product Specific Protocols | |
|---|---|
| IHC protocol for GRID1 antibody 13040-1-AP | Download protocol |
| IP protocol for GRID1 antibody 13040-1-AP | Download protocol |
| WB protocol for GRID1 antibody 13040-1-AP | Download protocol |
| Standard Protocols | |
|---|---|
| Click here to view our Standard Protocols |